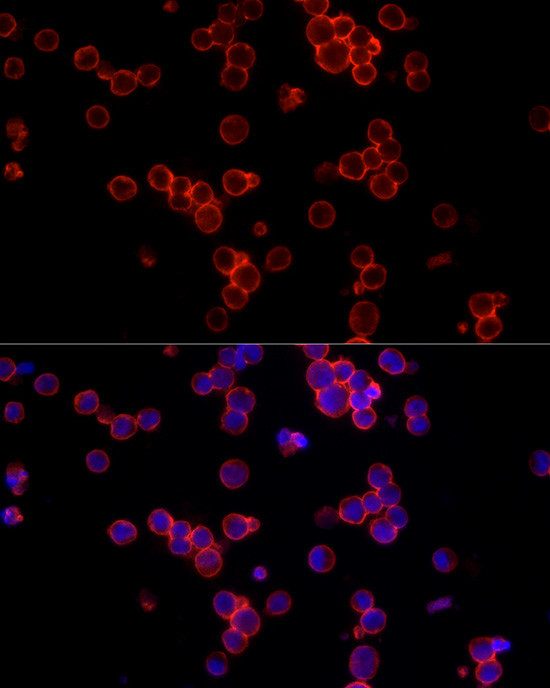
CD19 Antibody in Immunocytochemistry (ICC/IF)

Search
Invitrogen
CD19 Polyclonal Antibody
{{$productOrderCtrl.translations['antibody.pdp.commerceCard.promotion.promotions']}}
{{$productOrderCtrl.translations['antibody.pdp.commerceCard.promotion.viewpromo']}}
{{$productOrderCtrl.translations['antibody.pdp.commerceCard.promotion.promocode']}}: {{promo.promoCode}} {{promo.promoTitle}} {{promo.promoDescription}}. {{$productOrderCtrl.translations['antibody.pdp.commerceCard.promotion.learnmore']}}


Please note: We are reviewing Western blot images included in the antibody testing data in our catalog, including those provided by third parties. Unless expressly labeled or annotated as “raw-unedited”, Western blot images included in the antibody testing data in our catalog may have been edited, optimized or otherwise adjusted for presentation.
产品信息
PA5-109495
种属反应
宿主/亚型
分类
类型
抗原
偶联物
形式
浓度
规格
纯化类型
保存液
内含物
保存条件
运输条件
RRID
产品详细信息
Immunogen sequence: NAESYENEDE ELTQPVARTM DFLSPHGSAW DPSREATSLG SQSYEDMRGI LYAAPQLRSI RGQPGPNHEE DADSYENMDN PDGPDPAWGG GGRMGTWSTR
靶标信息
CD19 is a member of the immunoglobulin superfamily, characterized by two Ig-like domains, and is expressed on B cells throughout all stages of development, excluding terminally differentiated plasma cells. It is also expressed on follicular dendritic cells and has been observed on myeloid leukemia cells, particularly those of monocytic lineage. CD19 is considered the earliest and broadest B cell-restricted antigen, and its expression is found in all B cell precursor leukemias. CD19 forms a multimolecular complex with CD21, CD81, Leu13, MHC class II, and the B cell receptor (BCR), playing a crucial role in B cell signaling. As a signal-amplifying coreceptor for the BCR, CD19 lowers the threshold for antigen receptor-dependent stimulation, allowing B cells to respond specifically and sensitively to various antigens through low-affinity antigen receptors. Signaling through CD19 induces tyrosine phosphorylation, calcium flux, and proliferation of B cells. Beyond its role as a BCR coreceptor, CD19 can also signal independently of BCR co-ligation, serving as a central regulatory component upon which multiple signaling pathways converge. This makes CD19 an important functional regulator of both normal and malignant B cell proliferation. Mutations in the CD19 gene can result in hypogammaglobulinemia, a condition characterized by low levels of immunoglobulins, while CD19 overexpression can lead to B cell hyperactivity. CD19 is expressed on 100% of peripheral B cells, as defined by the expression of kappa or lambda light chains, underscoring its significance in B cell function and immune regulation.
仅用于科研。不用于诊断过程。未经明确授权不得转售。
篇参考文献 (0)
生物信息学
蛋白别名: B-lymphocyte antigen CD19; B-lymphocyte surface antigen B4; CD19; CD19 antigen; CD19 differentiation antigen; Differentiation antigen CD19; Leu-12; T-cell surface antigen Leu-12; unnamed protein product
基因别名: AW495831; B4; CD19; CVID3
UniProt ID: (Mouse) P25918
Entrez Gene ID: (Human) 930, (Mouse) 12478, (Rat) 365367